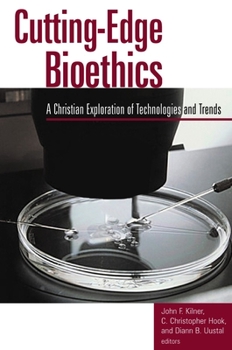
Paperback Cutting-Edge Bioethics: A Christian Exploration of Technologies and Trends Book

Cutting-Edge Bioethics: A Christian Exploration of Technologies and Trends
Select Format
Select Condition 
Book Overview
This book from the Center for Bioethics and Human Dignity provides a faith-based evaluation of recent technologies and trends in bioethics--including the current debate surrounding stem cell research.... This description may be from another edition of this product.
Format:Paperback
Language:English
ISBN:0802849598
ISBN13:9780802849595
Release Date:April 2002
Publisher:William B. Eerdmans Publishing Company
Length:216 Pages
Weight:0.79 lbs.
Dimensions:0.8" x 6.1" x 9.5"
Customer Reviews
0 rating